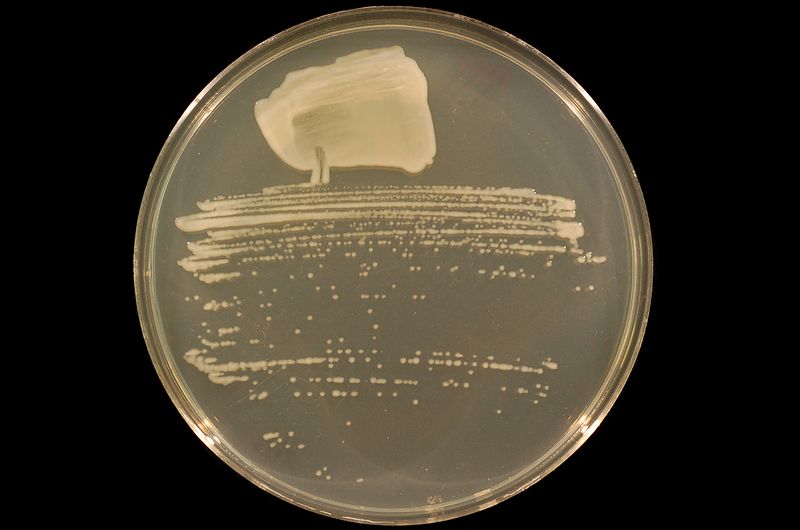

File:Sinorhizobium strain NGR234 on TY agar.JPG
From Wikimedia Commons, the free media repository
Size of this preview: 800 × 530 pixels. Other resolutions: 320 × 212 pixels | 640 × 424 pixels | 1,024 × 679 pixels | 1,280 × 849 pixels.
Original file (2,256 × 1,496 pixels, file size: 406 KB, MIME type: image/jpeg)
Summary[edit]
Description |
English: The bacterium Sinorhizobium sp. strain NGR234 streaked to single colonies on Tryptone-Yeast Extract (TY) agar.
|
Date | |
Source | Own work |
Author | Ninjatacoshell |
Licensing[edit]
I, the copyright holder of this work, hereby publish it under the following licenses:
You may select the license of your choice.
|
File history
Click on a date/time to view the file as it appeared at that time.
Date/Time | Thumbnail | Dimensions | User | Comment | |
---|---|---|---|---|---|
current | 01:57, 8 April 2011 | ![]() | 2,256 × 1,496 (406 KB) | Ninjatacoshell (talk | contribs) | Cleaned up, centered, and rotated. |
01:56, 8 April 2011 | ![]() | 2,256 × 1,496 (899 KB) | Ninjatacoshell (talk | contribs) | {{Information |Description ={{en|1=The bacterium ''Sinorhizobium'' sp. strain NGR234 streaked to single colonies on Tryptone-Yeast Extract (TY) agar.}} |Source ={{own}} |Author =Ninjatacoshell |Date =20 |
- You cannot overwrite this file.
File usage on Commons
The following page links to this file: